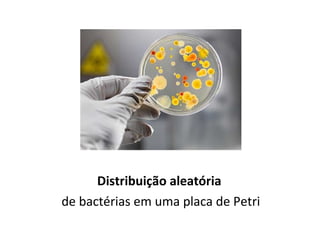
Distribuição aleatória
de bactérias em uma placa de Petri

O documento discute padrões espaciais em ecologia, abordando conceitos como padrões repetitivos e sua relação com a biodiversidade. Fatores abióticos, dispersão, competição e predação são destacados como determinantes dos padrões espaciais, além de apresentar diferentes tipos de distribuição espacial. O texto também menciona índices de dispersão, modelos de metapopulação e biogeografia de ilhas, visando compreender a estrutura espacial de populações e a distribuição de espécies.